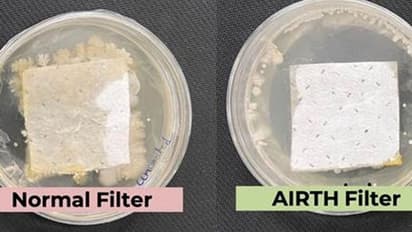
காற்றில் பரவும் தொற்று நோயை கட்டுப்படுத்தும், காற்றை சுத்தப்படுத்தும் புதிய வகை தொழில்நுட்பம் அறிமுகம்

புதிதாக உருவாக்கப்பட்ட காற்றை சுத்தப்படுத்தும் பில்டர், க்ரீன் டீயில் பொதுவாகக் காணப்படும் பொருட்களைப் பயன்படுத்தி, கிருமிகளை அழிக்கும் விதத்தில் உருவாக்கப்பட்டுள்ளது.
இது குறித்து மத்திய அறிவியல் மற்றும் தொழில்நுட்பத்துறை அமைச்சகம் சார்பில் வெளியிட்டுள்ள அறிவிப்பில் கூறியிருப்பதாவது
காற்று மாசு மனிதர்களின் வாழ்நாளைக் குறைத்து அவர்களின் வாழ்நாளில் 5 முதல் 10 ஆண்டுகள் வரை குறைத்துவிடும். ஏனென்றால், காற்றில் பரவும் கிருமிகளால் நுரையீரல் தொடர்பான நோயால் பாதிக்கப்பட்டு, மனநலமும் பாதிக்கப்படுகிறது என்று சிகாகோ பல்கலைக்கழகம் தெரிவித்துள்ளது.
கர்நாடகாவில் கட்டாயம் செல்ல வேண்டிய 10 இடங்களும் அதன் சிறப்பம்சங்களும்!!
பெங்களூருவில் உள்ள இந்திய அறிவியல் நிறுவனத்தின்(ஐஐஎஸ்சி) பேராசிரியர் சூர்யசாரதி போஸ் மற்றும் பேராசிரியர் கவுசிக் சாட்டர்ஜி ஆகியோர் சேர்ந்து ஓர் ஆய்வு நடத்தியுள்ளனர். அதில் “ கிரீன் டீயில் பொதுவாகக் காணப்படும் பாலிபினால்கள் மற்றும் பாலிகேஷனிக் பாலிமர்கள் போன்ற பொருட்களைப் பயன்படுத்தி கிருமிகளை கொல்லும் காற்று சுத்திகரிப்பான்களை உருவாக்கியுள்ளனர்.”
கொரோனா காலத்தில் சவாலான நேரத்தில் நடத்தப்பட்ட இந்த ஆய்வுக்கு தேவையான நிதியுதவி, ஆதரவை அறிவியல் மற்றும் பொறியியல் ஆராய்ச்சி வாரியம் மற்றும் எஸ்இஆர்பி டெக்னாலஜி டிரான்ஸ்லேஷன் அவார்ட்ஸ் ஆகியவை நிதியுதவியும், ஆதரவையும் வழங்கியுள்ளது.
தற்போதுள்ள காற்று சுத்திகரிப்புகளை தொடர்ச்சியான பயன்படுத்தும்போது, அதனால் உறிஞ்சப்பட்ட கிருமிகளின் இனப்பெருக்கம் செய்யும் இடமாக மாறும். இந்த கிருமிகளின் வளர்ச்சி காற்று சுத்திகரிப்பின் துளைகளை அடைத்து, காற்று சுத்திகரிப்பின் ஆயுளைக் குறைக்கிறது. அது மட்டுமல்லாமல் தொடர்ந்துஅதைப் பயன்படுத்தும் போது, மற்றவர்களின் உடலுக்கும் தீங்கு விளைவிக்கும்
இந்தியா பயங்கரவாதத்திற்கு எதிராக உலகை ஒன்றிணைக்கிறது… மத்திய அமைச்சர் அனுராக் தாக்கூர் தகவல்!!
இந்த புதிய ஆன்டிமைக்ரோபியல் காற்று சுத்திகரிப்பான்கள், என்ஏபிஎல் அங்கீகாரம் பெற்ற ஆய்வகத்தில் பரிசோதிக்கப்பட்டது. அதில் கோவிட் கிருமிகளை 99.24 சதவீதம் செயலிழக்கச் செய்யும் திறனுடையது என உறுதி செய்யப்பட்டது.
இந்த தொழில்நுட்பம் ஆராய்ச்சி மற்றும் பொருட்கள் மேம்பாட்டுப் பிரிவுக்கு மாற்றப்பட்டது ஆண்டிமைக்ரோபியல் வடிகட்டிகளை உருவாக்க , காற்றில் பரவும் நோய்க்கிருமிகளால் ஏற்படும் நோய்களைத் தடுக்கவும் இந்த புதிய கண்டுபிடிப்பு உறுதியளிக்கிறது இதற்காக 2022 இல் காப்புரிமை வழங்கப்பட்டது.
எதிரிகளின் ஏவுகணைகளை அழி்க்கும் ஐஎன்எஸ் ‘மர்மகோவா போர்க்கப்பல்’ அம்சங்கள் என்ன?
நமது ஏசிகள், சென்ட்ரல் டக்ட்ஸ் மற்றும் காற்று சுத்திகரிப்புகளி்ல் உள்ள இந்த புதிய ஆண்டிமைக்ரோபியல் ஃபில்டர்கள் காற்று மாசுபாட்டிற்கு எதிரான நமது போராட்டத்தில் முக்கிய பங்கு வகிக்கும் மற்றும் கொரோனா வைரஸ்கள் போன்ற காற்றில் பரவும் நோய்க்கிருமிகளின் பரவலைத் தடுக்கும்